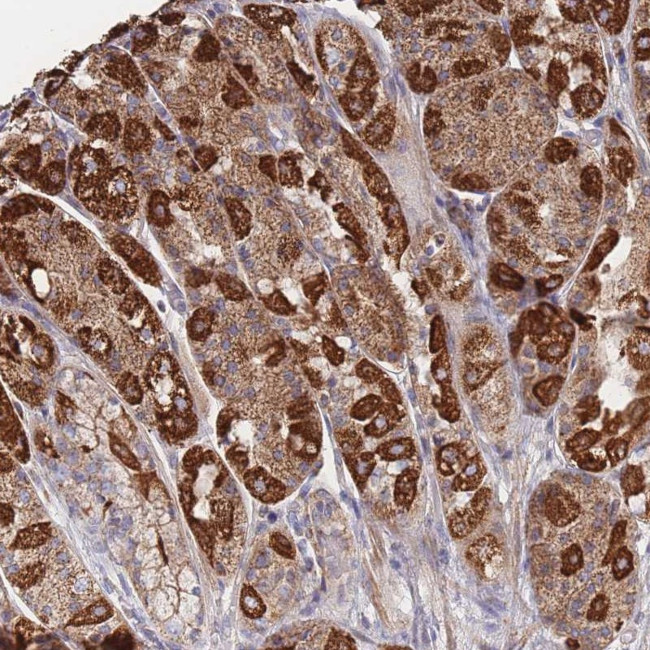
IKZF4 Antibody in Immunohistochemistry (Paraffin) (IHC (P))

Search
Invitrogen
IKZF4 Polyclonal Antibody
{{$productOrderCtrl.translations['antibody.pdp.commerceCard.promotion.promotions']}}
{{$productOrderCtrl.translations['antibody.pdp.commerceCard.promotion.viewpromo']}}
{{$productOrderCtrl.translations['antibody.pdp.commerceCard.promotion.promocode']}}: {{promo.promoCode}} {{promo.promoTitle}} {{promo.promoDescription}}. {{$productOrderCtrl.translations['antibody.pdp.commerceCard.promotion.learnmore']}}
产品信息
PA5-61861
种属反应
宿主/亚型
分类
类型
抗原
偶联物
形式
浓度
规格
纯化类型
保存液
内含物
保存条件
运输条件
RRID
产品详细信息
Immunogen sequence: LQLQLYLPSC SLLQGSGDSS LEKEFLGAPV GPSVSTPNSQ HSSPSRSLSA NSIKVEMYSD EESSRLLGPD ERLLEKDDSV IVEDSLSEPL GYCDGSG
Highest antigen sequence identity to the following orthologs: Mouse - 84%, Rat - 84%.
靶标信息
DNA-binding protein that binds to the 5'GGGAATRCC-3' Ikaros-binding sequence. Transcriptional repressor. Interacts with SPI1 and MITF to repress transcription of the CTSK and ACP5 promoters via recruitment of corepressors SIN3A and CTBP2. May be involved in the development of central and peripheral nervous systems.
仅用于科研。不用于诊断过程。未经明确授权不得转售。
篇参考文献 (0)
生物信息学
蛋白别名: Ikaros family zinc finger protein 4; similar to Ikaros; unnamed protein product; Zinc finger protein Eos; zinc finger protein, subfamily 1A, 4 (Eos); zinc finger transcription factor Eos
基因别名: EOS; IKZF4; KIAA1782; ZNFN1A4
UniProt ID: (Human) Q9H2S9
Entrez Gene ID: (Human) 64375